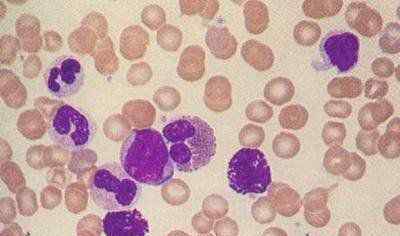

什么是急性白血病
急性淋巴细胞白血病是急性白血病的一种类型,是指白血病细胞起源于淋巴系统,包括原始淋巴细胞和幼稚淋巴细胞,具体分为B细胞急性淋巴细胞白血病和T细胞急性淋巴细胞白血病;多见于儿童和青少年。
目前急性白血病或慢性白血病的病因尚不明确,可能与病毒感染、电离辐射、化学物质有关,但确切病因尚不清楚,即目前尚无ALL的病因,但若平时进行适当的体育锻炼、规律的作息、规律的饮食有利于预防各种疾病。
原因是什么
1.物理因素:电离辐射可诱发白血病。
2.化学因素:所有能引起骨髓增生的化学物质都有白血病的可能,尤其是苯及其衍生物对造血组织有抑制作用,可引起白血病。

3.遗传因素:
一些遗传病常伴有白血病高发。如唐氏综合征易患急性粒细胞白血病和急性淋巴细胞白血病,比正常儿童高15-20倍左右。

4.病毒因素:
一些病毒被证实与淋巴细胞白血病有关,如人类T细胞病毒和EB病毒。


急性淋巴细胞白血病的临床表现有哪些?
患者经常会突然感到发冷、发烧、头痛、疲劳、疲惫、食欲不振、恶心、呕吐、腹痛和腹胀,并经常有皮肤、鼻子、嘴和牙龈出血。严重者可出现呕血、便血、血尿、眼底出血、颅内出血,并迅速发展为进行性贫血。其特点包括:
一般症状:发病迅速,多数患者表现为发热、进行性贫血、出血或关节痛。
发热:主要原因是感染,常见于呼吸道、泌尿系统、肛周等。感染病灶不明显,严重者可引起败血症。


出血:全身都有出血,尤其是皮肤下、口腔、鼻腔。颅内出血、消化系统和呼吸道大出血可导致死亡。


贫血:患者早期可出现面色苍白、心悸、乏力、呼吸困难等。


急性淋巴细胞白血病应该做哪些临床检查?
血象白细胞计数增高,可见未成熟淋巴细胞和不典型淋巴细胞。血小板正常或减少。


骨髓增生活跃至极度活跃,幼稚和原始淋巴细胞占25%以上。

流式细胞术:确定细胞的免疫表型
急性淋巴细胞白血病必需抗体
急性B淋巴细胞白血病亚型的分类
急性淋巴细胞白血病亚型的分类
染色体和遗传检查:
一、Ph1染色体检查有助于确诊和指导治疗及预后。


B.聚合酶链反应-基因分型:
1.43融合基因筛选+WT1定量;
2.定量BCR-阿布勒(P210,P190,P230);
3.T-ALL定性PCR: SIL/TAL 1在1P32染色体微缺失;
筛选出33个与4。类ph ALL。
鱼类基因分型:
1.儿童全鱼:bcr/abl,tel/AML,MLL,myc,10.4,P53
成年全鱼:bcr/abl,MLL,igh,myc,p16,P53。
如何诊断急性淋巴细胞白血病?
如遇上述情况,立即去医院!把问题留给专家解决。
根据病史、临床表现、血象和骨髓象、流式细胞术、染色体和基因可明确诊断。
ALL应该和哪些疾病区分开来?
1.白血病样反应:外周血白细胞增多明显和/或出现幼稚白细胞时称为白血病样反应,通常引起中毒、肿瘤、失血、溶血药物等。,NAP评分显著增加。白血病样反应去除诱因后可以恢复正常,红细胞和血小板不受影响,很难与白血病区分。此时可以通过免疫遗传学等方法仔细鉴别。
2.再生障碍性贫血:出血性贫血、发热、全血减少与ALL伴白细胞减少相似,易与发育不全性白血病混淆。肝脾淋巴结不肿大,骨髓增生低,未增加原始幼稚细胞比例。
3.恶性组织细胞增生症:该病为单核-巨噬细胞系统恶性增生性疾病,临床可表现为发热、贫血、出血、肝、脾、淋巴结肿大,全身广泛浸润性病变,难以与白血病相鉴别。如果见到大量吞噬组织细胞,出现异常组织细胞,则支持对该病的诊断。恶性组织细胞增生症,缺乏特异性诊断手段,有骨髓影像支持但不符合临床的不能确诊,有临床支持但不符合骨髓影像的不能排除。所以,病要靠综合分析。骨髓和淋巴结活检可以提供一些证据。
4.传染性单核细胞增多症:该病由爱泼斯坦-巴尔病毒感染引起,伴有发热、皮疹型心绞痛、肝脾淋巴结肿大;血象中白细胞的增多主要是由淋巴细胞增多引起的,淋巴细胞的变异往往达到10%以上。
5.风湿类风湿性关节炎:发热、关节痛、贫血、白细胞增多等。与ALL相似,但肝、脾、淋巴结不肿大,通过骨髓检查不难区分。
6.骨髓增生异常综合征(MDS)是由受损造血干细胞引起的一组病态造血和功能障碍性骨髓疾病。本病主要表现为贫血,少数病例可伴有不同程度的出血、肝脾肿大和淋巴结肿大,以及骨痛。20% ~ 30%的病例最终转变为急性白血病,该病的骨髓象显示病理性三、二系或任意一系造血。
得了急性淋巴细胞白血病怎么办?
如果你有急性淋巴细胞白血病,最重要的是给予积极的治疗,包括全身化疗。部分患者需要造血干细胞移植,部分或少数急性淋巴细胞白血病可以治愈,应积极治疗。
急性淋巴细胞白血病能治好吗?
急性淋巴细胞白血病来源不同,预后不同。相对而言,B细胞急性淋巴细胞白血病预后好于T细胞急性淋巴细胞白血病,儿童急性淋巴细胞白血病更常见。儿童急性淋巴细胞白血病也是一种预后相对较好的急性白血病。

这次科普教育的目的是介绍急性淋巴细胞白血病的诊断。请关注后期科普教育的内容。
1.《急性淋巴细胞白血病能治愈吗 什么是急性淋巴细胞白血病?》援引自互联网,旨在传递更多网络信息知识,仅代表作者本人观点,与本网站无关,侵删请联系页脚下方联系方式。
2.《急性淋巴细胞白血病能治愈吗 什么是急性淋巴细胞白血病?》仅供读者参考,本网站未对该内容进行证实,对其原创性、真实性、完整性、及时性不作任何保证。
3.文章转载时请保留本站内容来源地址,https://www.lu-xu.com/guoji/1641253.html













